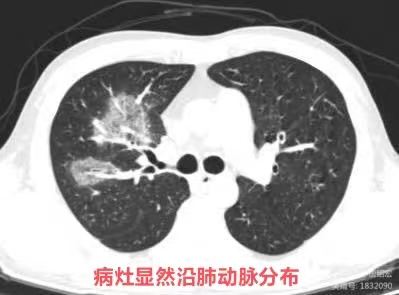
图片

如何在肺 CT 上一眼识别致病菌? | 读片挑战第 10 弹
男,36 岁,患者于 7 天前无明显诱因出现干咳,周身不适,发热,体温最高 39℃,自行口服退烧药(具体不详),在当地诊所治疗 5 天(不详),1 天前咳嗽剧烈伴呼吸困难来诊。
- 反晕征病灶沿气管血管束分布,能分清是沿肺动脉分布?还是沿支气管分布?
肺毛霉菌病

临床上围绕血管的渗出非常容易形成反晕征(上图红色箭头),而支气管的渗出不形成反晕征(上图蓝色箭头看似反晕征的中心是支气管,实际上是影像层面显示的原因,肺动脉没有显示出来)。
首先了解肺毛霉菌病的常见发生诱因有二:1. 是糖尿病血糖控制不佳,有酮症时出现,2. 是血液病时发生。
影像上三种表现形式:1. 单纯的血管侵袭可以出现反晕征(如本例),血管截断征、空洞及实变(但本例未出现);2. 单纯的支气管肺侵袭,出现树芽征(主要特征),磨玻璃影及沿支气管的实变;3. 同时有血管、支气管肺侵袭。